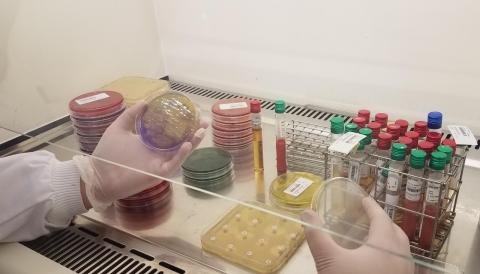

Le laboratoire d'analyses de biologie médicales du centre hospitalier de Jonzac ouvert au public
Modifié le 15/01/2025
Notre laboratoire fait partie du groupement inter-hospitalier GCS de Haute Saintonge comprenant les établissements de Jonzac, Saintes, Royan et Saint-Jean d’Angély.
Vous pouvez réaliser tous les prélèvements (adulte et enfant) prescrits par votre médecin traitant ou votre médecin spécialiste avec ou sans rendez-vous.
Les analyses sont traitées sur site par notre équipe d’experts.
La prise de rendez-vous peut s’effectuer :
Par téléphone du lundi au vendredi de 7h30 à 17h00 et le samedi de 8h00 à 12h00
au 05.46.48.75.12
(pas de prélèvement le samedi matin, uniquement prise de rendez-vous et remise des résultats)
Sur place, au secrétariat médical situé au rez-de-chaussée du Centre Hospitalier de Jonzac, 4, avenue Winston Churchill
(suivre le fléchage « » au sol du bureau des entrées à l’entrée du laboratoire)
» au sol du bureau des entrées à l’entrée du laboratoire)
Les biologistes se tiennent à votre disposition pour toute question avant l’examen ainsi que pour vous commenter vos résultats.
Les résultats vous seront remis par notre secrétariat en main propre ou pourront vous être envoyés à votre domicile. Le médecin prescripteur recevra une copie de votre bilan soit par courrier soit via une messagerie sécurisée.
